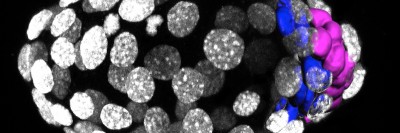

At Memorial Sloan Kettering, we’re always looking to further our understanding of where cancer comes from and how it develops.
A new study in mice led by Kathryn Anderson, Chair of the Developmental Biology Program in the Sloan Kettering Institute, showed that a mutation in the PTEN gene that’s been linked to many kinds of cancer can also cause birth defects of the nervous system.
This research, recently published in the journal eLife, shows how the mutation affects cell shape and prevents cells from properly forming important body structures.
It helps us to understand how the same mutation in this gene might later give rise to cancer.
Developmental Biology and Cancer’s Origins
The cells in our body contain the same DNA throughout our lives. This DNA provides all the instructions needed to create and sustain life. But sometimes those instructions include errors, also known as genetic mutations.
When these errors are present early in development, they can lead to birth defects. Later in life, the same errors can lead to different problems, including the formation of cancer and other diseases.
The field of developmental biology is helping us to understand the role that various genes play in the formation of embryos — both when these genes function normally and when they’re mutated. It can provide insight into the role of these same genes in mature cells, including how mutations might give rise to cancer.
“Studying development in lab animals like zebrafish and fruit flies is important for the understanding of human disease,” Dr. Anderson says. “There’s still a big conceptual gap between these funny-looking fruit flies and cancer therapy, but as laboratory techniques are getting increasingly powerful, more and more researchers are able to make those connections.”
A Common Cancer Mutation
One gene mutation that’s been well studied, in PTEN, is the second most common mutation found in tumors. Cancer researchers have focused on it for many years in an attempt to understand how the faulty version of PTEN enables cancer to develop.
“PTEN mutations have been found in rare hereditary genetic conditions that are characterized by both neurological problems and increased cancer risk, such as Cowden syndrome and Bannayan-Riley-Ruvalcaba syndrome,” Dr. Anderson says. “Human PTEN syndromes are also linked to some cases of autism spectrum disorder.”
Her team analyzed the embryonic development of mice that were modified to have mutations in the PTEN gene. They demonstrated that PTEN mutations led to birth defects characterized by problems with the neural tube — the structure in embryos from which the brain and spinal cord form. These birth defects included spina bifida, in which the bottom of the spinal column remains open, and anencephaly, in which the brain and skull fail to fully develop.
A Focus on Tissue Structure
“In cancer, PTEN mutations are especially common in tumors of the epithelial tissues, such as prostate, breast, endometrium [uterus], and brain cancers,” Dr. Anderson says.
The epithelium — one of the four types of body tissue — lines cavities and surfaces throughout the body.
Epithelial cells are also responsible for the formation of the neural tube, which is the first step in the development of the nervous system. “So it makes sense that the PTEN mutations would play a role in developmental problems with the brain and spinal cord, which are made of epithelial tissue,” she adds.
When mouse embryos are about nine days old, flat sheets of epithelial cells roll into what becomes the neural tube, allowing the nervous system to begin taking shape.
But in mice with PTEN mutations, Dr. Anderson’s study — which also included MSK Physician-in-Chief José Baselga — showed that the sheets fail to roll up properly. Further, the experiments showed that this failure occurs because the cells are unable to properly organize themselves into layers.
“The organization of cells within the epithelial layers is important for them to be able to form various tissues,” she says.
Looking Beyond Individual Cells
“A lot of what we know about PTEN we’ve learned from studying cell cultures,” Dr. Anderson says. “An important question going forward for cancer biology is to look at the way that PTEN affects epithelial organization, and why the organization impacts cancer in certain kinds of tissue more than others.”
“In human PTEN syndromes — where in many cases people have one functioning copy and one mutant copy — this reduction in PTEN activity plays a role in more subtle defects than what we saw in these mice that had no PTEN, most of whom did not survive after birth,” she adds. “And on the cancer side, it has helped remind us that cancers are not merely a function of a few rogue cells going berserk in isolation. It’s important to look at cancer cells in the context of whole tissues.”
This work was supported by the National Institutes of Health grants R37 HD03455 and R01 NS044385 to Dr. Anderson and the MSK Cancer Center Support Grant (P30 CA008748).